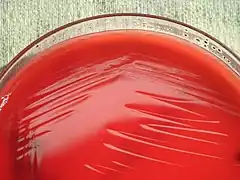
Description de l'image Kingella kingae PHIL12451.jpg.

Kingella kingae
| Domaine | Bacteria |
|---|---|
| Division | Proteobacteria |
| Classe | Betaproteobacteria |
| Ordre | Neisseriales |
| Famille | Neisseriaceae |
| Genre | Kingella |
Espèce
Henriksen et Bøvre 1968
Kingella kingae est un petit bacille ou cocco-bacille à Gram négatif, de culture lente, aérobie strict et préférant une atmosphère enrichie en CO2. Elle fait partie de la flore oropharyngée, mais peut se révéler être un authentique pathogène, surtout chez le jeune enfant.
Sa mise en évidence est assez récente puisqu'elle remonte à l'année 1960 ; ce n'est toutefois que depuis les années 1990 que son rôle en tant que pathogène est reconnu. Précédemment nommée Moraxella kingii, cette bactérie est connue depuis 1976 sous le nom de Kingella kingae, d'après Elizabeth O. King, bactériologiste américaine l'ayant mise en évidence pour la première fois en 1960.
K. kingae est retrouvée essentiellement chez le jeune enfant. Elle est responsable d'infections potentiellement graves : arthrites septiques, ostéomyélites, spondylodiscites, bactériémies, endocardites et plus rarement de méningites et d'infections du tractus respiratoire inférieur[1]. Les infections à K. kingae sont souvent précédées par une infection rhinopharyngée.
K. kingae est sensible à de nombreux antibiotiques : bêta-lactamines, érythromycine, fluoroquinolones. L'évolution sous antibiothérapie est le plus souvent favorable, à l'exception des endocardites. En effet, K. kingae appartient aux bactéries du groupe HACEK, un ensemble de bacilles à Gram négatif de croissance lente et responsables d'endocardites parfois difficiles à traiter.
Au laboratoire, la mise en évidence de K. kingae peut se révéler difficile, et l'inoculation directe de flacons d'hémoculture à partir du liquide articulaire ou de fragments de valves cardiaques peut être nécessaire au diagnostic.
Notes et références
- ↑ (en) Yagupsky P. « Kingella kingae: from medical rarity to an emerging paediatric pathogen » Lancet Infectious Disease, 2004;4(6):358-367.
- Portail de la médecine
- Portail de la microbiologie